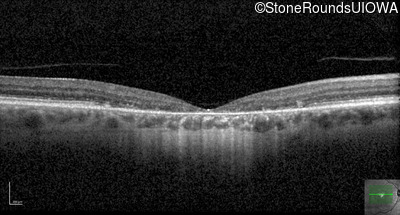
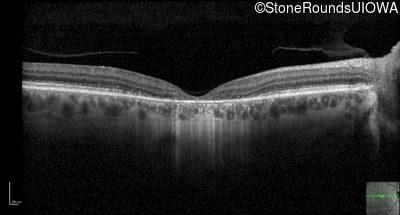
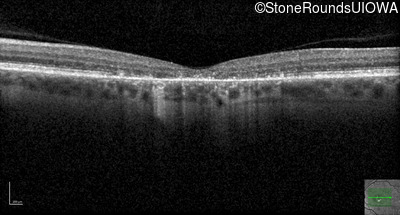
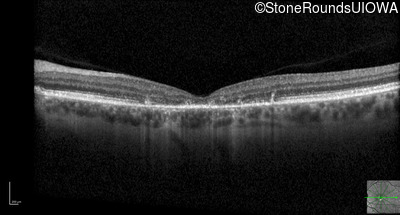
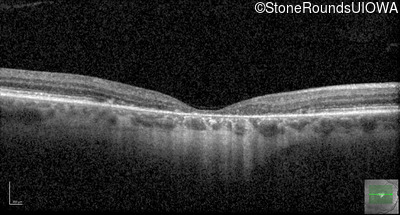
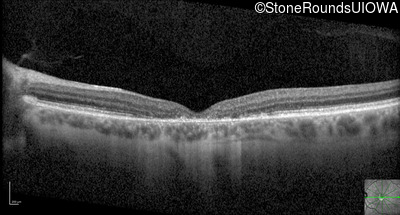

Case
SR2574
Student Mode
AR Stargardt Disease (IIA)
Male
Male
Hidden
SR2574
Student Mode
AR Stargardt Disease (IIA)
Male
Male
Visit at age: 53 years
Fundus Photography - Right - 20/200 +2
Fundus Photography - Left - 20/50 -1
Fundus Montage - Right - 20/200 +2
Fundus Montage - Left - 20/50 -1
Goldmann Visual Field - Right - 20/200 +2
Goldmann Visual Field - Left - 20/50 -1
Optical Coherence Tomography - Right - 20/200 +2
Optical Coherence Tomography - Left - 20/50 -1
Infrared Fundus Photograph - Right - 20/200 +2
Infrared Fundus Photograph - Left - 20/50 -1
Blue Autofluorescence - Right - 20/200 +2
Blue Autofluorescence - Left - 20/50 -1
Visit at age: 54 years
Goldmann Visual Field - Right - 20/160 -2
Goldmann Visual Field - Left - 20/160 +1
Optical Coherence Tomography - Right - 20/160 -2
Optical Coherence Tomography - Left - 20/160 +1
Infrared Fundus Photograph - Right - 20/160 -2
Infrared Fundus Photograph - Left - 20/160 +1
Case Level Images

Diagnosis & molecular findings
| Disease | Gene | Allele 1 variant(s) | Allele 2 variant(s) | Inheritance mode |
|---|---|---|---|---|
| AR Stargardt Disease | ABCA4 | IVS40+5 G>A | Gly1961Glu GGA>GAA | AR |
Disease:
Gene:
Allele 1:
IVS40+5 G>A
Allele 2:
Gly1961Glu GGA>GAA
Inheritance:
AR